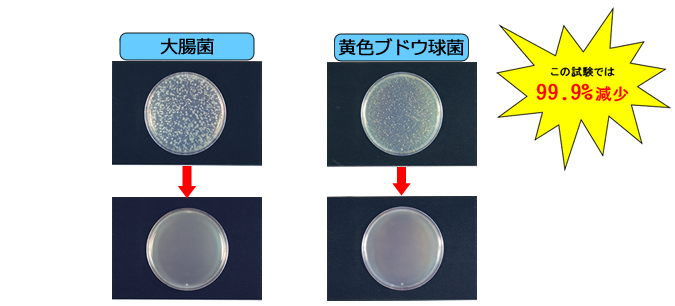

| 分類 | 目的 | 用途 |
| 住居 | 抗菌・防黴・消臭・感染 | 壁紙・キッチンカウンター・押入れ壁・靴収納庫 |
| 病院 | 抗菌・消臭・院内感染 | 待合室・病院・手術室 |
| 学校 | 抗菌・消臭・感染 | 施設・壁・天井・机 |
| 介護施設 | 抗菌・消臭・感染 | 施設内・テーブル・給食室 |
| 食品工場 | 抗菌・消臭・感染 | 工場内・壁・天井・作業テーブル |
| 飲食店舗 | 抗菌・消臭・感染 | 店舗内・壁・天井・カウンター・テーブル |
| ペット | 消臭・感染 | ペットマンション・壁・天井 |
|
| 分類 | 目的 | 用途 |
| 住居 | 抗菌・防黴・消臭・感染 | 壁紙・キッチンカウンター・押入れ壁・靴収納庫 |
| 病院 | 抗菌・消臭・院内感染 | 待合室・病院・手術室 |
| 学校 | 抗菌・消臭・感染 | 施設・壁・天井・机 |
| 介護施設 | 抗菌・消臭・感染 | 施設内・テーブル・給食室 |
| 食品工場 | 抗菌・消臭・感染 | 工場内・壁・天井・作業テーブル |
| 飲食店舗 | 抗菌・消臭・感染 | 店舗内・壁・天井・カウンター・テーブル |
| ペット | 消臭・感染 | ペットマンション・壁・天井 |
| 試験菌 | 対象 | 接種直後 | 24h後 |
| 大腸菌 | ナノシルバー | 2.1×100,000 | <10 |
| 大腸菌 | 無処理 | 2.1×100,000 | 2.6×10,000,000 |
| 黄色ブドウ球菌 | ナノシルバー | 1.9×100,000 | <10 |
| 黄色ブドウ球菌 | 無処理 | 1.9×100,000 | 1.7×100,000 |